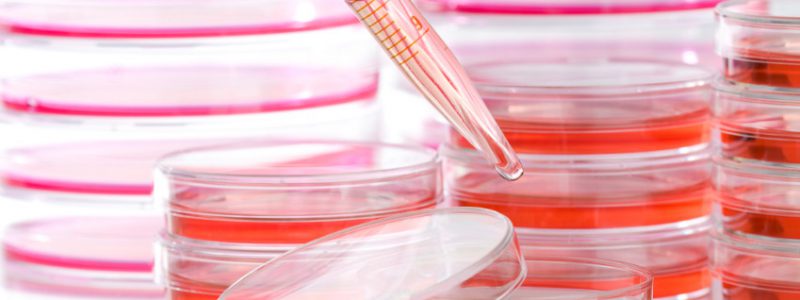

Licht, …camera, …actie!

Tijdens de nominatie van de Beauty Award word je er al een beetje voor klaargestoomd: interviews, fotoshoots en video-opnames. Direct na het winnen van de Award, toen we van het grote podium afkwamen stond het team van Beautyspot.nl al klaar met een camera en microfoon voor het eerste interview dat ik als kersverse Schoonheidsspecialist van…